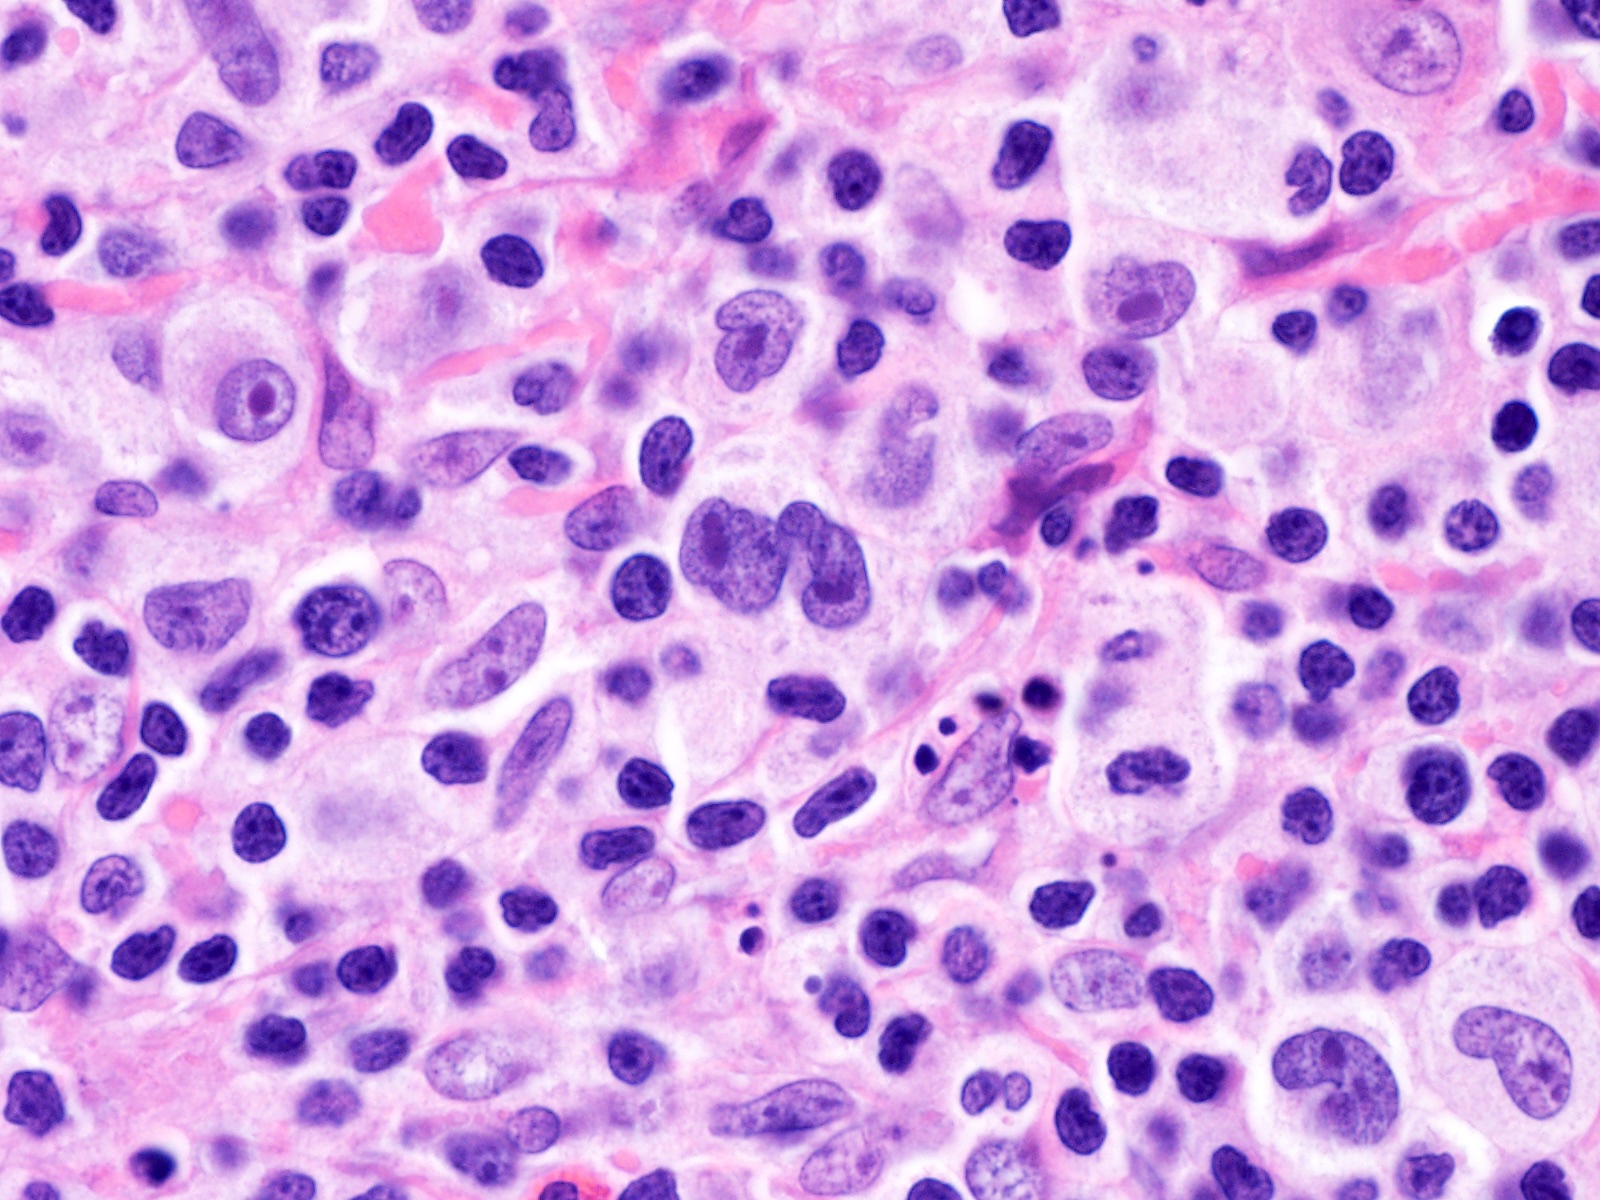
Hodgkin's Disease

Spotting CentrePathology
Pathology LessonsPathology
Disease Processes & Lesion Recognition
Examine each slide systematically — architecture first, then cellular detail — before reading the annotated lesson notes.
15
Lessons
4
Easy
7
Medium
4
Hard
15 lessons Go to Spot Test
Ready to be tested?
Take the Pathology Spot Test — 15 shuffled slides, point-writing, instant scoring.